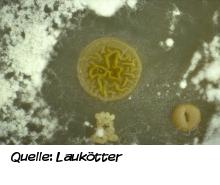
Natürliches Recycling

B2 Natürliches Recycling
Natürliches Recycling
Wie sieht es im Waldboden aus?
Wenn Sie dem Höhenweg in den Witthausbusch folgen, dann treffen Sie an einer Hangflanke auf einen Bodenanschnitt. Hinter einer Tür im oberen Teil des Bodenprofils verbirgt sich ein dunkler Oberboden. In der Auflage sind teilweise zersetzte Pflanzenreste zu erkennen. Mit ein wenig Glück sind größere Bodentiere wie Würmer, Asseln oder Schnecken einen kurzen Augenblick sichtbar.
Im unteren Teil des Bodenprofils können neugierige Besucher den typisch gelb-braunen Unterboden finden, der sich aus fruchtbarem Lösslehm entwickelt hat.
Natürlicher Buchenwald
Je nach Bodenbeschaffenheit und Klima fühlen sich ganz bestimmte Baumarten an einem Ort wohl. Im Witthausbusch sind die Bedingungen für die Rotbuche ideal. Hier hat sich der natürliche Waldtyp erhalten: ein Buchenwald. Ob das in Zukunft so bleibt, ist nicht sicher. Denn das Klima verändert sich. Wird der Boden zu trocken, hat es die Rotbuche schwer und andere Baumarten übernehmen.

Fleißige Recycling-Teams
Der Oberboden ist ein reich besiedelter Lebensraum. In einer Handvoll fruchtbaren Boden leben mehr Lebewesen als Menschen auf der gesamten Erde. In den oberen 30 Zentimetern eines Bodens leben unzählige Organismen: Bakterien, Pilze, Milben, Asseln, Springschwänze, Insektenlarven, Würmer, Maulwürfe, Mäuse und viele andere mehr. Sie leben in einer stark verflochtenen Lebensgemeinschaft zusammen und sind eng an ihre Umgebung angepasst.
Die meisten Bodenlebewesen sind so klein, dass wir sie mit bloßem Auge kaum erkennen können. Sie haben aber eine wichtige Aufgabe: sie zerkleinern und zersetzen abgestorbene Teile von Pflanzen, Tieren und Pilzen bis hin zu ihren anorganischen Grundstoffen und wandeln Streu in Humusstoffe. Der Humus dient wiederum den Pflanzen als Nahrung. „Müll“ gibt es in der Natur nicht. Der Abfall des einen ist die Nahrung des anderen. So befindet sich alles in einem natürlichen Kreislauf.
Lernen Sie hier einige der fleißigen Helfer kennen::

Wurmartige Erdvermischung
Diesen Bodenbewohner kennt jedes Kind: den Regenwurm. Er ernährt sich von abgestorbenem Pflanzenmaterial. Regenwürmer können sich bis in diesen Unterboden vorarbeiten. Sie lockern und vermischen so Minerale und Humus und sorgen für wasserleitende Poren. Dank der Regenwurmgänge können sich Luft und Wasser im Boden gut verteilen. Auch Pflanzenwurzeln wachsen leichter in die Tiefe.

Rollassel und Kellerassel
Asseln sind etwa 1 cm groß. Mit ihren 14 Beinen gehören sie zu den Krebstieren und sind nah mit Garnelen oder Krabben verwandt. Im Boden leben sie vor allem im Laub oder altem Holz, von dem sie sich ernähren. Als Zersetzer von groben Materialien haben sie eine äußerst wichtige Funktion. Häufigste Asselarten sind Keller- und Mauerassel. Wer eine Assel findet, die sich in der Hand einrollt, hat eine Rollassel entdeckt.
Bakterien und Pilze
Mikroorganismen im Boden sind ungeheuer wichtig, da sie kleinste organische Materialien abbauen, die Nährstoffe daraus für die Pflanzen verfügbar machen und außerdem Nahrung für winzige Tiere sind. Bakterien sind mit einer Größenordnung von 1 µm (Mikrometer = 1 millionstel Meter) die winzigsten Organismen im Boden und meist nur mit einem guten Mikroskop zu erkennen. In nur einem Gramm Boden leben über 100 Millionen Bakterien, darunter Tausende verschiedene Arten. Nur die allerwenigsten Pilze treten in Form der bekannten Ständerpilze auf. Zahllose mikroskopisch kleine Pilzfäden durchziehen den Boden. Manche von ihnen leben in enger Gemeinschaft mit Pflanzen und liefern ihnen Nährstoffe. Dafür spendet die Pflanze Zuckerverbindungen, die sie in ihren Blättern aufgebaut hat.

Springschwanz
Diese 1 bis 2 mm langen Tiere mit dem lustigen Namen zählen mit ihren sechs Beinen zu den Insekten. Im Laub leben auf 1 m² Waldboden gut 50.000 dieser Tiere, darunter zahlreiche verschiedene Arten von Springschwänzen. Die Allesfresser besitzen zwar keine Flügel, aber einen besonders guten Sprungapparat, mit dem sie sich wie mit einem Katapult fortbewegen. Das kann man beobachten, wenn man eine Handvoll Laub aufhebt und genau hinsieht.
Kompost
Kompostieren im eigenen Garten lohnt sich, denn damit können Sie fruchtbaren Gartendünger selbst herstellen. Es gibt vielfältige Möglichkeiten der Kompostierung: vom einfachen Komposthaufen bis zum professionellen Kompostbehälter. Wichtig ist dabei eine gute Mischung der biologischen Abfälle aus verschiedenen Haushalts- und Gartenabfällen, sodass der Kompost weder zu trocken noch zu feucht ist. In den Kompost gehören Haushaltsabfälle wie Gemüse-, Obst- und sonstige Speisereste, Tee- und Kaffeesatz, Eierschalen und Haustierstreu. Gut kompostierbare Gartenabfälle sind Laub und Pflanzenreste, Gehölzschnitt und Stauden verträgt der Kompost nur in geringer Menge und gut zerkleinert.
Lebensraum Kompost
Ganz nebenbei schaffen Sie durch das Anlegen eines Komposts im Garten einen wertvollen Lebensraum für viele Tiere. Darin können Sie einen wichtigen Baustein der Nahrungskette beobachten, nämlich den Abbau von organischem Material und die Humusbildung.
Im Kompost leben nicht nur die direkten Verwerter des toten Pflanzenmaterials. Auch Amphibien, Reptilien und Igel nutzen gerne die hier entstehende Wärme und das reichhaltige Nahrungsangebot.

Weiterführende Informationen:
- Bodentiere beobachten
- Ratgeber zur Herstellung von Kompost






